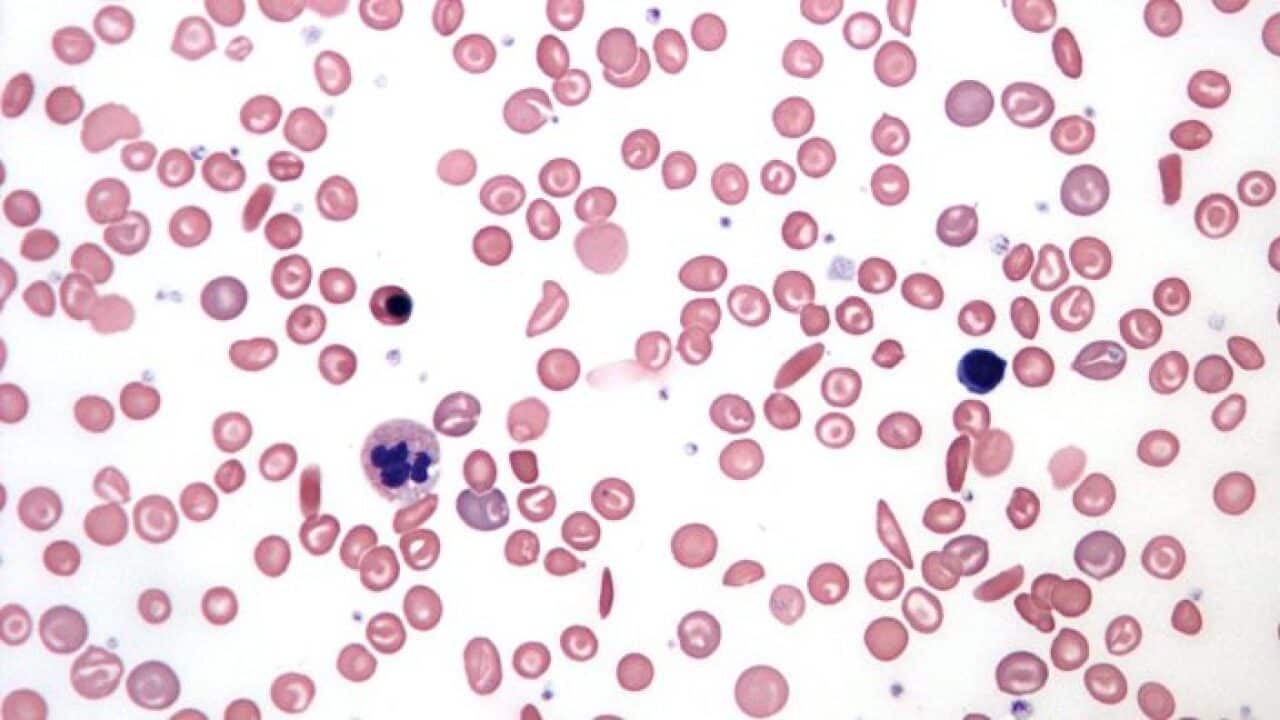
A blood smear showing abnormally shaped red blood cells caused by sickle-cell anemia.

مرض خلية المنجل أو فقر الدم المنجلي يصيب أكثر من 250 مليون شخص في العالم. هو وهو من أكثر أمراض الدم الوراثية شيوعًا في العالم.
ذكر تقرير طبي حديث ان هذا المرض يصيب أكثر من 250 مليون شخص في العالم. هو وهو من أكثر أمراض الدم الوراثية شيوعًا في العالم ويؤثر هذا المرض بشكل خاص على أولئك الذين ينتمون إلى أقليات عرقية متنوعة في أستراليا وبالتالي يؤثر على التركيبة السكانية في استراليا والتي تتغير بوتيرة أسرع من أي وقت مضى.
وقال الدكتور حامد المفرجي اخصائي أمراض القلب والأوعية الدموية إنهُ تم تسمية مرض فقر الدم المنجلي بهذا الاسم لان الخلية تصبح تشبه المنجل وهو الاداة التي يستخدمها الفلاح للحصاد فهي تكون عبارة عن الهلال وفيها مقبض. وتكون الخلية بنفس شكل المنجل لذا تسمى بخلية المنجل. أما الخلية السليمة فتكون عادة مدورة ومقعرة.

وأضاف الدكتور المفرجي، في حديثِ مع برنامج أستراليا اليوم، أن الخلايا المنجلية هي اضطراب دم وراثي تتطور فيه خلايا الدم الحمراء (كرات الدم الحمراء) التي تحمل الأكسجين حول الجسم بشكل غير طبيعي.
في فقر الدم المنجلي يصبح شكل الخلية مشوه، وتصبح جامدة وتشكل كالهلال (أو المنجل). خلايا الدم الحمراء على شكل المنجل تفكك بسهولة، مسببة الأنيميا .لا يمكن لخلايا الدم المنجلية أن تعمل بشكل صحيح وتخضع لموت مبكر (تعيش فقط أيام 10-20 بدلاً من أيام 120 العادية).
تحتوي الخلايا المنجلية على هيموجلوبين معيب. الأشخاص المصابين بأمراض الخلايا المنجلية يصنعون شكلا مختلفا من الهيموجلوبين A يسمى الهيموغلوبين S (S يقف على المنجل هذه الخلايا غير الطبيعية غير قادرة على التحرك بسهولة مثل الخلايا الشكلية الشكل ويمكن أن تمنع الأوعية الدموية، مما يؤدي إلى تلف الأنسجة والأعضاء ونوبات شديدة وهذه الخلايا تتجمع معا وتلتزم بجدران الأوعية الدموية، وتعرقل تدفق الدم.
وتعرف هذه الآلام العرضية باسم أزمة الخلايا المنجلية أو أزمة انسداد الأوعية. قد لا يعرف الشخص ما الذي يسبب الألم ، لكن العدوى والجفاف هما من العوامل الشائعة. يمكن أن تستمر من بضع دقائق إلى عدة أشهر ، على الرغم من أن معظمها في المتوسط آخر خمسة إلى سبعة أيام.
تحتوي خلايا الدم الحمراء على الهيموغلوبين وهو بروتين يحمل الأكسجين في الدم. خلايا الدم الحمراء الطبيعية ناعمة ودائرية ومرنة (يمكنها الضغط عبر الأوعية الدموية الصغيرة) ، مما يتيح لها الانتقال عبر الأوعية الدموية الصغيرة لتوصيل الأكسجين إلى جميع أنحاء الجسم. عادة ، تعيش خلايا الدم الحمراء لمدة 120 يوم تقريبًا قبل خلايا جديدة استبدلهم.
المزيد في التدوين الصوتي اعلاه مع الدكتور حامد المفرجي اخصائي أمراض القلب والأوعية الدموية